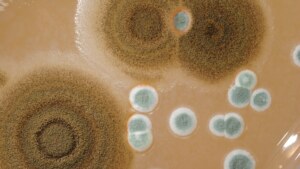

July 8, 2026 in News
A New Standard for Building Commissioning
Standards Australia has published the new Australian Standard AS 5342 - Building Commissioning to address the needs of various stakeholders including ...
December 5, 2024

During the year, industry experts from across A.G. Coombs provide useful building services advice through our Advisory Notes.
For your convenience and easy reference, you’ll find recent Advisory Notes consolidated below:
We hope you find Advisory Notes a valuable source of practical information
and insight.
On behalf of A.G. Coombs teams everywhere, we look forward to keeping you informed in 2025.
Visit the A.G. Coombs website to see the complete library of 65 Advisory Notes.

Modern fire protection systems are now often integrated into other building systems and require a comprehensive testing approach to assure they will operate in line with the building’s fire safety strategy when required.

Over the past decade, automated data analytics have been seamlessly integrated into various facets of our daily lives, including the operation and maintenance of buildings such as commercial offices, educational facilities, infrastructure, and healthcare establishments. As facility owners, managers, and building service providers embrace this advanced technology, the methods for collecting, storing, and analysing operational building data have evolved significantly.
Mould plays an important role in the natural environment as a break-down mechanism for dead organic matter. In the built environment it is an unwanted presence and a particular problem in the warm and humid conditions experienced in much of Australia. Unpleasant and unsightly, it can damage fabric and equipment and is a threat to the health of occupants.

A lot has changed since we released our first Advisory Note on heat pumps back in 2018. Increasingly, building owners are no longer asking if heat pumps should be installed to replace fossil fuel-fired heating technology, but instead are asking when – and how.

Building owners and facility managers often don’t have access to a full set of accurate documentation for of their buildings to support effective and safe ongoing operation, maintenance and modifications. This limits the ability to manage a building over its lifecycle and ensure occupant safety and regulatory compliance.

As the construction and property sectors continue to develop and embrace new technologies including digital twins, cognitive buildings, artificial intelligence and machine learning, there is a need to ensure that data systems are suitable to maximise the potential value and return on investment.

In response to the identification of potential risks to workers from electric shock and arc flash, an Australian Standard has been updated to provide new guidelines for the principles for safe working.

The principle on which fire sprinklers operate is a simple one and has been the same since they were invented in 1806, the automatic discharge of water on a fire. It is still the most practical and effective method to control fire in a building. This advisory note explains the principles behind automatic fire sprinkler systems, common reasons for system failure and a key test for older systems that is often overlooked.

Soaring gas prices, uncertainty around the validity of carbon offsets and updates to the National Greenhouse Accounts emissions factors are just some of the reasons that building owners are switching off their trigeneration and cogeneration plants. This Advisory Note provides an overview of the drivers for decommissioning trigeneration systems and sets out typical issues that need to be addressed.

With the increasing demand for electric vehicles, particularly in urban centres, provision of suitable charging infrastructure must be considered within buildings.
Advisory Notes published by A.G. Coombs are a longstanding information service developed to keep our valued customers and colleagues better informed and up to date on building issues, particularly in the changing areas of regulatory and industry standards.
Subscribe to receive new Advisory Notes delivered straight to your inbox in 2025.

July 8, 2026 in News
Standards Australia has published the new Australian Standard AS 5342 - Building Commissioning to address the needs of various stakeholders including ...

July 7, 2026 in News
NAIDOC Week 2026 marks a significant milestone, celebrating 50 years of recognising and honouring the histories, cultures and achievements of Aborigin...

June 26, 2026 in News
World Refrigeration Day 2026 will focus on the essential role of cooling and sustainable heating through this year’s global theme — Cool Intellige...

June 23, 2026 in News
International Women in Engineering Day (INWED), celebrated globally on 23 June, recognises the achievements and contributions of women engineers while...